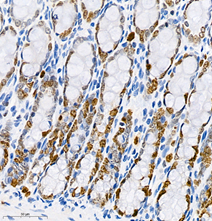

KI67
- 100ul
Product Information
Description | Ki67 rabbit polyclonal |
Protein full name | Proliferation marker protein Ki-67 |
Synonyms | MKI67, marker of proliferation Ki-67, KIA, MIB-1, PPP1R105 |
Immunogen | KLH conjugated Synthetic peptide corresponding to Mouse Ki67 |
Isotype | IgG |
Purity | Affinity purification |
Subcellular location | Nucleus |
Uniprot ID | E9PVX6 |
Applications
applications | species | dilution | Positive tissue |
IHC | Mouse, Rat | 1: 500-1: 1000 | colon, placenta |
IF | Mouse, Rat | 1: 600-1: 1200 | testis, colon |
Background
Required to maintain individual mitotic chromosomes dispersed in the cytoplasm following nuclear envelope disassembly (PubMed:27362226). Associates with the surface of the mitotic chromosome, the perichromosomal layer and covers a substantial fraction of the chromosome surface (PubMed:27362226). Prevents chromosomes from collapsing into a single chromatin mass by forming a steric and electrostatic charge barrier: the protein has a high net electrical charge and acts as a surfactant, dispersing chromosomes and enabling independent chromosome motility (PubMed:27362226). Binds DNA, with a preference for supercoiled DNA and AT-rich DNA (By similarity).
Images
| Immunohistochemistry analysis of paraffin-embedded mouse placenta using Ki67 (GB111141) at dilution of 1: 500 |
| Immunohistochemistry analysis of paraffin-embedded mouse colon using Ki67 (GB111141) at dilution of 1: 500 |
| Immunofluorescent analysis of paraformaldehyde-fixed mouse testis using Ki67 (GB111141) at dilution of 1: 1200 |
| Immunofluorescent analysis of paraformaldehyde-fixed rat colon using Ki67 (GB111141) at dilution of 1: 1200 |
Storage
| Storage | Store at -20 ℃ for one year. Avoid repeated freeze/ thaw cycles. |
| Storage Buffer | PBS with 0.02% sodium azide, 100 μg/ml BSA and 50% glycerol. |
NOTE:
1.This product is intended for research only.
2.This product is recommended to dilute with the Primary Antibody Dilution Buffer (G2025).
| 货号 | 名称 | 规格 | 价格 | 操作 |
|---|
| 货号 | 名称 | 规格 | 价格 | 操作 |
|---|